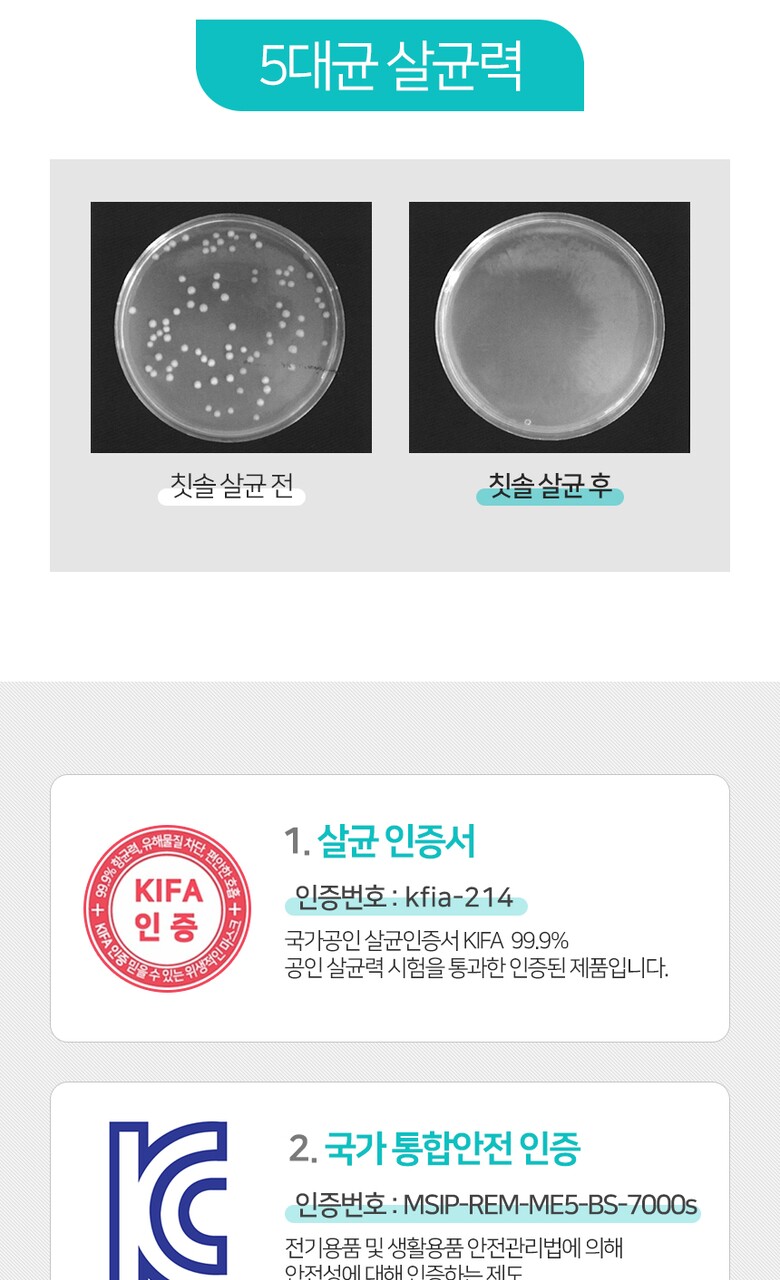

오투케어브랜드 SHOP
O2케어 POP아노다이징 오픈형 칫솔살균기 24시간 살균 건조 Ti500
칫솔살균기
오투케어 베스트 상품
PRODUCT VIEW

리뷰를 작성해주시면 일반리뷰는 50포인트
포토 리뷰는 100포인트를 적립해 드립니다.
1. 모델명(품번) | O2케어 POP아노다이징 오픈형 칫솔살균기 24시간 살균 건조 Ti500 |
---|---|
2. 제조국 | 대한민국 |
3. 전기용품 안전인증 필 유/무 | [전기용품]안전인증_국가인증 JH07601-11002G |
4. 동일모델의 출시년월 | 2023.01 |
5. 전기안전인증 | 인증필함 |
6. 크기/무게(폭x높이x깊이)(cm) | 상세페이지 참조 |
7. 정격전압,소비전력 | 전격전압: 220V / 60Hz , 소비전력: 6W(사용전력 5.3W) |
8. 제조사(수입자) | 제조자: 메디슨주식회사 |
9. 에너지소비효율등급 | 상세페이지 참조 |
10. 품질보증기준 | 제품 이상시, 공정거래위원회 고시 소비자 분쟁해결기준에 의거 보상 |
11. A/S책임자와전화번호 | 메디슨주식회사 031-574-6103 |
12.추가설치비용 | 해당사항없음 |
마리오몰 배송안내 |
|
---|---|
마리오몰 교환 및 반품 안내 |
교환
반품
반품 유의사항
|
기타 기준 사항 |
상품불량에 의한 반품, A/S, 품질보증 및 피해보상 등에 관한 사항은 소비자 분쟁해결기준(공정거래위원회 고시) 구매자가 미성년자인 경우에는 상품 구입시 법정대리인이 동의하지 아니하면 미성년자 본인 또는 법정대리인이 구매취소 할 수 있습니다. |
전동칫솔·구강세정 베스트 상품